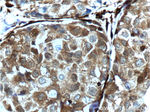
Galectin-1 Antibody in Immunohistochemistry (Paraffin) (IHC (P))
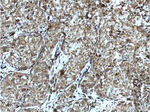
Galectin-1 Antibody in Immunohistochemistry (Paraffin) (IHC (P))

Search
Proteintech
Galectin-1 Polyclonal Antibody
{{$productOrderCtrl.translations['antibody.pdp.commerceCard.promotion.promotions']}}
{{$productOrderCtrl.translations['antibody.pdp.commerceCard.promotion.viewpromo']}}
{{$productOrderCtrl.translations['antibody.pdp.commerceCard.promotion.promocode']}}: {{promo.promoCode}} {{promo.promoTitle}} {{promo.promoDescription}}. {{$productOrderCtrl.translations['antibody.pdp.commerceCard.promotion.learnmore']}}
产品信息
11858-1-AP
种属反应
已发表种属
宿主/亚型
分类
类型
抗原
偶联物
形式
浓度
规格
纯化类型
保存液
内含物
保存条件
运输条件
产品详细信息
Immunogen sequence: MACGLVASN LNLKPGECLR VRGEVAPDAK SFVLNLGKDS NNLCLHFNPR FNAHGDANTI VCNSKDGGAW GTEQREAVFP FQPGSVAEVC ITFDQANLTV KLPDGYEFKF PNRLNLEAIN YMAADGDFKI KCVAFD (1-135 aa encoded by B C020675)
靶标信息
Galectin-1 belongs to a large family of carbohydrate-binding proteins called lectins. Galectin-1can be either monomeric or homodimeric and is found in a wide variety of cells and tissue types. Galectin-1 can control cell growth, proliferation, induce apoptosis of activated T cells while it can also modulate cytokine secretion or inhibit pro-inflammatory cytokine production. Galectin-1 plays an important role in acute and chronic inflammation.
仅用于科研。不用于诊断过程。未经明确授权不得转售。
生物信息学
蛋白别名: 14 kDa laminin-binding protein; 14 kDa lectin; beta-galactoside binding protein; Beta-galactoside-binding lectin L-14-I; beta-galactoside-binding protein 14kDa; DKFZp686E23103; epididymis secretory sperm binding protein; Gal-1; Galaptin; Galectin-1; Galectin1; H-Galectin-1; HBL; HLBP14; HPL; Lactose-binding lectin 1; Lectin galactoside-binding soluble 1; lectin precursor; lectin, galactose binding, soluble 1; lectin, galactoside-binding, soluble, 1; LGALS1; pm12; Putative MAPK-activating protein PM12; RL 14.5; S-Lac lectin 1; unnamed protein product
基因别名: AA410090; Gal-1; GAL1; Galbp; galectin-1; GBP; L-14.5; L14; Lect14; LGALS1
UniProt ID: (Human) P09382, (Mouse) P16045, (Rat) P11762
Entrez Gene ID: (Human) 3956, (Mouse) 16852, (Rat) 56646